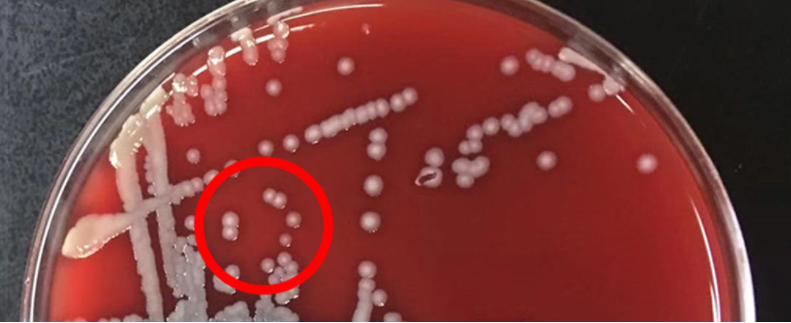

- Un studiu de la Universitatea Wuhan a descoperit o singură enzimă responsabilă pentru depresia unor femei în timpul anilor de reproducere.
- Studiul a comparat nivelurile de estradiol din serul de sânge al a 91 de femei cu depresie și a 98 femei fără depresie.
- Scăderea nivelului de estradiol poate fi legată de depresia la persoanele cu hormoni feminini fertili.
Un nou studiu realizat de cercetători de la Universitatea Wuhan a descoperit o singură enzimă care poate fi responsabilă pentru depresia unor femei în timpul anilor de reproducere, legând astfel interacțiunea complexă dintre hormoni, intestine și sănătatea mentală.
Studiul a comparat nivelurile de estradiol din serul de sânge al a 91 de femei cu depresie și a 98 femei fără depresie. Rezultatele au arătat că femeile cu depresie aveau aproape jumătate din nivelurile serice de estradiol față de cele fără depresie. Aceste descoperiri sugerează că scăderea nivelurilor de estradiol poate fi legată de depresia la persoanele cu hormoni feminini fertili.
Afecțiuni precum sindromul ovarelor polichistice și hiperplazia suprarenală congenitală pot provoca, de asemenea, scăderea nivelurilor de estradiol și depresie, explicând astfel de ce depresia este de două ori mai frecventă la femei decât la bărbați. Estradiolul este produs în ovare, fiind responsabil pentru reglarea ciclurilor menstruale și este metabolizat în ficat și apoi trecut în intestin, scrie Sciencealert.
În intestine, hormonul este parțial reabsorbit înapoi în fluxul sanguin pentru a menține nivelurile de estrogen în circulație. Prin urmare, cercetătorii au investigat activitățile estradiolului în intestin pentru a descoperi legătura acestuia cu depresia.
Nivelurile scăzute de estradiol la femeile cu depresie sunt legate de activitatea unui anumit microb intestinal
Ei au descoperit că nivelurile scăzute de estradiol la femeile cu depresie sunt legate de activitatea unui anumit microb intestinal, Klebsiella aerogenes TS2020. Studiul a arătat că acest microb este responsabil pentru degradarea estradiolului în sistemul nostru digestiv. După ce au adăugat estradiol în probe de microbiom de la femeile cu depresie, s-a înregistrat o degradare a hormonului de 78%, comparativ cu o scădere de 20% în probele de la femeile fără depresie. Cercetătorii au izolat apoi tulpina de bacteria responsabilă pentru degradarea estradiolului, etichetând-o drept Klebsiella aerogenes TS2020.
Cercetătorii au descoperit că bacteriile intestinale, în special tulpina numită Klebsiella aerogenes TS2020, poate reduce nivelul seric de estradiol la șoareci și poate induce comportamente de tip depresiv. Această bacterie transformă estradiolul în estronă cu ajutorul unei enzime numite 3β-HSD (3β-hidroxisteroid dehidrogenază). Analiza genetică a arătat că plasarea genei pentru această enzimă în E. coli și apoi infectarea șoarecilor cu aceste bacterii a dus la aceeași scădere a estradiolului și la apariția simptomelor depresive. Administarea de cefotaxime, un antibiotic specific pentru K. aerogenes, a atenuat comportamentele depresive la șoareci.
Această enzimă transformă estradiolul în estronă, iar nivelurile scăzute de estradiol au fost asociate cu simptomele depresive la șoareci. În plus, cercetătorii au descoperit că nivelurile crescute ale aceleiași enzime au fost prezente la pacienții depresivi de sex masculin. Cu toate acestea, terapia de substituție cu estrogen poate avea limitări din cauza bacteriilor producătoare de 3β-HSD. În schimb, bacteriile care degradează estradiolul în intestin ar putea fi considerate ca ținte terapeutice mai eficiente.
Citește și
- Bacteriile intestinale – cheia tratamentului pentru cancer?
- Trecerea la ora de vară 2023. Când să mergi la culcare pentru a te trezi odihnit
- De ce e important să aștepți două ore între administrarea acestor medicamente?
The post STUDIU: O singură enzimă ar putea cauza depresia. Cum afectează sănătatea femeilor appeared first on Aleph News.
potrivit alephnews

Lasă un răspuns